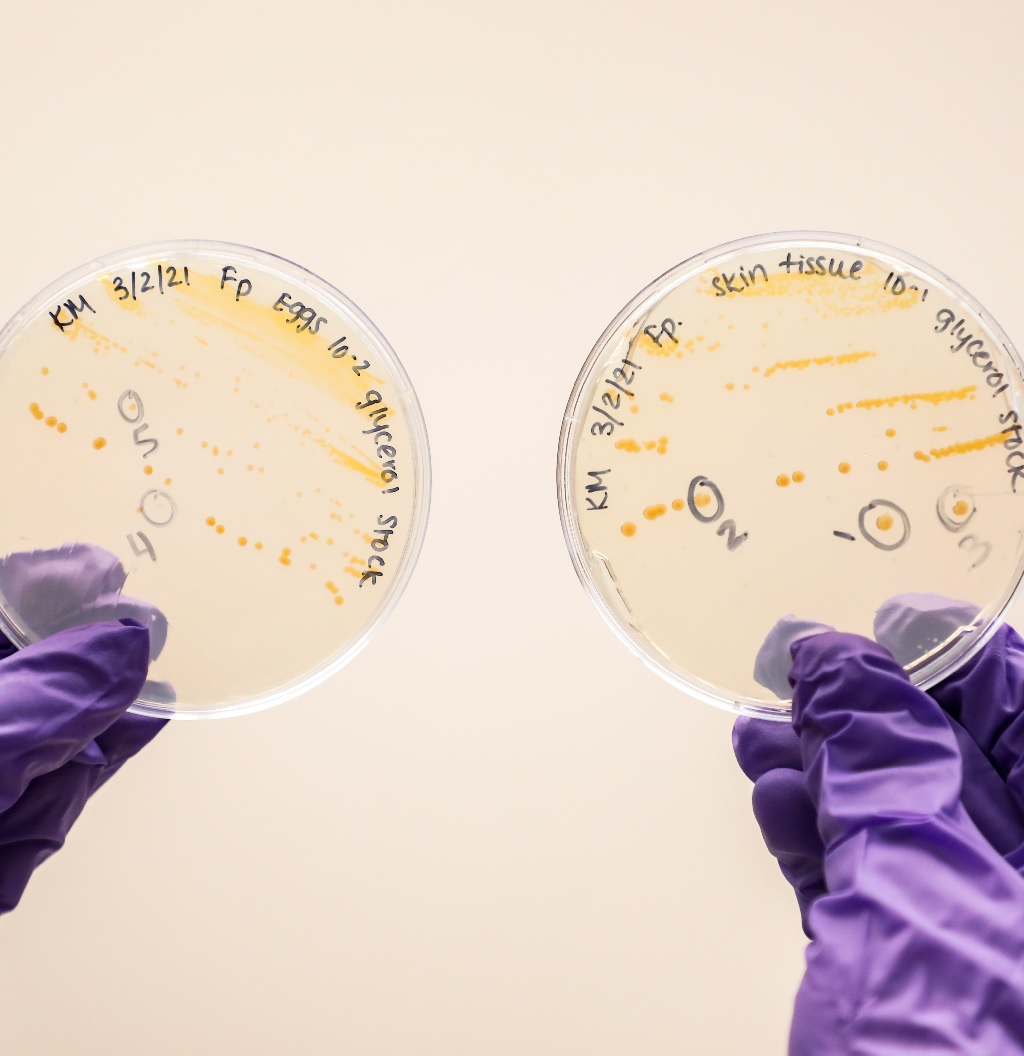

E.M. Tech - Electron Microscopy Laboratory at Montana Tech



Explore the microscopic universe with our state-of-the-art scanning/transmission electron microscope!
In May of 2023, courtesy of funding from the National Science Foundation (Award Number 2216488), the Montana Tech Department of Biological Sciences acquired a state-of-the-art Hitachi HT7820 scanning/transmission electron microscope. The new E.M.Tech laboratory is open to researchers and students of Montana Tech and the Montana University System who require high resolution imaging or elemental analysis for samples appropriate for a TEM. Thanks to support from the National Institutes of Health Science Education Partnership Award (NIH SEPA,Grant Number: 5R25GM132951), the E.M.Tech facility will also work with statewide K-12 science and engineering education outreach programs.
NEW OXFORD Xplore TEM EDS DETECTOR INSTALLED and READY FOR SAMPLES! As of February 2024 Oxford Xplore TEM Energy Dispersive Spectroscopy (EDS) detector is available for use with the Hitachi HT7820 TEM. This instrumentation was provided by ARL funding to Dr. Jack Skinner. Please contact EMsignup@mtech.edu to discuss your samples and to schedule your time on the microscope with Dr. Driver.
E.M.Tech’s mission is to advance interdisciplinary research, education, and outreach in Biology, Chemistry, Geochemistry, Mechanical Engineering, Environmental Engineering, and Geology. E.M. Tech will impact students at the K-12 to PhD level as well as scientists throughout the region.
The vision of the E.M.Tech Electron Microscopy Laboratory is to be the premier provider of transmission electron microscopy with microanalysis capabilities at Montana Tech and the Montana University System. E.M.Tech will strive to be a go-to site for expert consultation on sample collection, preparation, and training for a variety of TEM imaging techniques.
Outreach and educational goals
- Exposure to and use of the electron microscope will help inspire an interest in science, technology, engineering, and mathematics (STEM) careers by K-12 students and teachers served by the Clark Fork Watershed Education Program (CFWEP) and the Montana Bureau of Mines and Geology.
- The ability to capture and convey the beauty of the biological, mineral and nano-scale worlds to K-12 students will spark interest in scientific careers, increase science literacy, and has the potential to combat scientific misinformation.
- The E.M.Tech facility was established to significantly benefit state-wide outreach activities and underrepresented groups in Montana, including students from rural, economically disadvantaged areas, and Native American communities.
- The microscope’s images will engage students by visualizing and scientifically characterizing viruses, minerals, nanomaterials, as well as the results of environmental damage and restoration.
- Exposure to these electron microscopy capabilities will increase student recruitment and retention, increase entry to STEM careers, and strengthen science and technology in Montana.


Users
- Faculty and Researchers at Montana Tech and in the Montana University System
- Undergraduate and Graduate Student researchers at Montana Tech, including
- PhD students in Material Science and Earth Science Engineering at Montana Tech
- K-12 educators and students via Clark Fork Watershed Education Program (CFWEP)
- Montana Bureau of Mines and Geology
- Montana Tech Laboratory Courses
- Plans for commercial use are in development
E.M. Tech Hitachi 7820
In May of 2023, courtesy of funding from the National ScienceFoundation (Award Number 2216488), the Montana Tech Department of Biological Sciences acquired a state-of-the-art Hitachi HT7820 scanning/transmission electron microscope. This 120 kV TEM has a “Dual Mode” compound objective lens system that can operate in either high contrast or high resolution (HC/HR) mode for standard TEM imaging. The HT7820 includes a Scanning Transmission Electron Microscope unit with both a brightfield and a darkfield detectors. While TEM uses a broad, parallel electron beam to obtain an image of a sample the scanning TEM uses a focused beam to scan the sample line by line. This scanning technique provides an ultra-high-resolution image of a sample in either brightfield or darkfield view. Additionally, the HT7820 will be equipped with an Oxford AZtecEnergy Energy Dispersive X-ray Spectroscopy (EDS) Microanalysis system. The EDS will allow elemental identification, localization, and mapping of elements of interest in a sample.
E.M.Tech is managed by Dr. Jim Driver, an electron microscopist with over 15 years of experience in a variety of techniques for both scanning and transmission electron microscopy. Dr. Driver will be available for consultation on sample collection and preparation for standard TEM imaging, scanning TEM, EDS, and analysis using the Hitachi HT7820. Facility users will provide samples and reagents to capture images with user training and instrument support by Dr. Driver.
Plans for commercial use are in development. Interested commercial usersplease provide input as to your anticipated needs within the Microscope Anticipated Commercial Use Form.




Take a peek at the incredible images the E.M. Tech team has been able to capture with the Hitachi HT7820 scanning/transmission electron microscope.

The Montana Standard wrote an article about the exciting new possibilities the E.M. Tech lab will have with the purchase of a Hitachi HT7820.
The National Science Foundation (NSF) Public Abstract provides addition information about how this high-powered microscope will provide opportunities to southwestern Montana.
The Hitachi HT7820 in the new E.M.Tech laboratory is open to researchers and students of Montana Tech and the Montana University System (including the MBMG) at no charge. Users will be trained in and responsible for sample preparation.
Microscopist: Dr. Jim Driver
EMsignup@mtech.edu